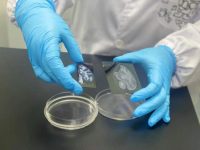
世界首套獼猴大腦皮層單細胞空間分布圖譜發布!G60腦智科創基地取得腦科學領域引領性成果 世界首套獼猴大腦皮層單細胞空間分布圖譜發布!G60腦智科創基地取得腦科學領域引領性成果

-

吸納新鮮血脈,致力新時期大學科技園創新發展
為探討新形勢下大學科技園如何推進產學研合作和科技成果轉移轉化工作,開展科技園發展模式及經驗交流,7月18日、19日,由長三角六所理工科大學、七個所屬科技園組成的長三角高等工程教育...
區縣風采2023.7.21來源:上海楊浦 -
世界首套獼猴大腦皮層單細胞空間分布圖譜發布!G60腦智科創基地取得腦科學領域引領性成果
大腦是人體最復雜的器官,破譯大腦運轉密碼,揭開生命之謎,是令無數科學家殫精竭慮的艱難課題。近日,經過中國科學院腦科學與智能技術卓越創新中心(神經科學研究所)、華大生命科學研究院...
區縣風采2023.7.21來源:上海松江 -

帶動元宇宙產業高質量發展!這家企業上海研發中心在“大零號灣”啟用
7月19日上午,歌爾光學上海研發中心啟用儀式在“大零號灣”華誼萬創·新所舉行。上海交通大學黨委常委、副校長奚立峰,閔行區委副書記、區長陳華文,區委常委、副區長趙亮,歌爾股份有限公...
區縣風采2023.7.20來源:今日閔行 -

上海松江以高水平制度供給推動創新,打造洞涇人工智能產業基地
7月19日,松江區黨建引領人工智能產業集群工作推進會暨“AI松江·人文洞涇·創智未來”科技活動月啟動儀式在洞涇鎮舉行,探索把黨組織建在產業集群上,將人工智能產業上下游企業緊密聯系在一...
區縣風采2023.7.20來源:上觀新聞 -

從綠水青山中尋得“金山銀山”,松江企業為節能減排貢獻智慧
在高樓林立的國際金融中心辦公場所,在鑿地而行的軌道交通地下空間,在城市濱江道路兩側,在國內外多地加油站……這是上海九高節能技術股份有限公司(以下簡稱“九高節能”)繪制的業務版圖。董...
區縣風采2023.7.19來源:上海松江 -

浦東商業板塊又添亮色!這個重點商旅文項目要來了
金橋路535號,原上海航海儀器總廠,正更新蛻變成為氛圍感十足的活力街區——EKA·天物。在今年上半年舉行的浦東新區國際消費中心全球推介大會上,中船航海與嘉韻投資合作的“EKA·天物”作為重點商...
區縣風采2023.7.18來源:浦東發布 -

上海首條“新一代智慧公路”試運行!橫貫閔行浦江兩岸
記者近日從上海城投獲悉,上海首條“新一代智慧公路”S32申嘉湖智慧高速公路試運行。S32申嘉湖智慧高速公路全長83.512公里,運用大數據、邊緣計算、人工智能、數字孿生等信息技術,以建設全要...
區縣風采2023.7.17來源:今日閔行 -

虹橋前灣首個超級產業園區正加速建設,集辦公、商業、公寓、服務于一體!
上海正在加速打造全球電競之都,位于華漕的虹橋前灣是主戰場之一。記者獲悉,華漕電競產業板塊的智匯前灣園區四期項目“LOOP星環中心”正在加速建設,從高空俯瞰,錯落有致的13棟樓宇匯聚成鉆...
區縣風采2023.7.17來源:今日閔行 -

“兩舊一村”改造加快推進!這個街道最大的成片不成套公房小區整體簽約率100%
記者從新區“兩舊一村”改造推進指揮部辦公室獲悉,7月12日晚上,隨著最后一戶完成簽約,作為2023年新區“兩舊一村”首批啟動的重點項目之一,滬東新村街道向東新村2個地塊共564產居民全部完成...
區縣風采2023.7.14來源:浦東發布 -

浦東康橋新建雨水泵站下挖五層樓,夏季區域排澇不再難
日前,浦東新區康橋路雨水泵站新建工程超深地下連續墻順利實現閉合,迎來工程重要節點。建成后將能有效解決雨水排放問題,保障區域夏季防汛安全。 康橋路雨水泵站新建工程于去年12月開工...
區縣風采2023.7.13來源:上觀新聞

